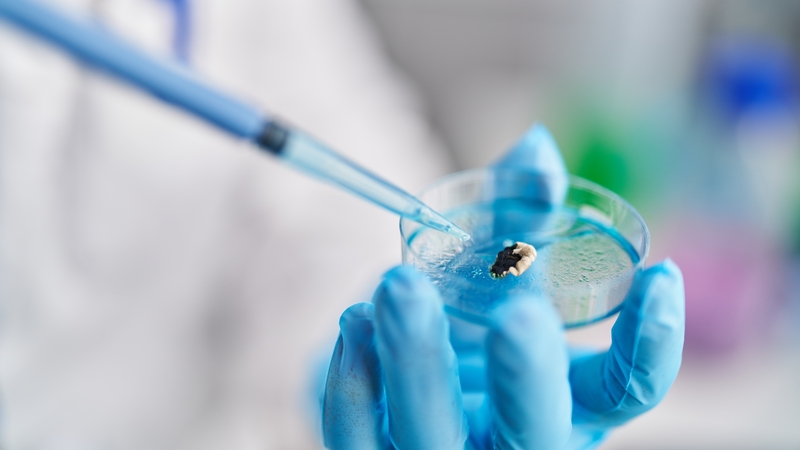
'Many insect models are currently available, but the use of larvae of the wax moth, Galleria mellonella, has been found to be most advantageous'. Photo: Getty Images

Analysis: insects are now being used to study the efficiency of novel anti-microbial and other drugs
The process of transforming a concept into a drug involves careful planning and multiple stages. It begins with identifying a therapeutic target, such as a protein or enzyme linked to a specific disease. Researchers use various techniques, including biological data science (bioinformatics) and study of genes (genomics) to find these potential targets. Once a target is identified, chemists design molecules that could interact with it, typically with the help of computational chemistry.
The next step involves making these compounds in the laboratory. Chemists use techniques such as chemical synthesis, which combines different chemical reagents under specific conditions to create the desired molecule. This stage may require several attempts to refine the compound's structure and enhance its properties.
Following synthesis, the compounds undergo in vitro testing. In vitro testing refers to experiments conducted in a controlled environment outside a living organism. "In vitro" is Latin for "in glass," which originally described experiments done in glass containers like test tubes or petri dishes. In this type of testing, scientists study how a drug interacts with cells or biological molecules. For example, they might add a drug to a dish containing cells taken from a human or an animal to see if it kills harmful bacteria or stops cancer cells from growing.
Insects' capacity to live in variable conditions and climates is suggestive of a highly effective immune response
These tests help researchers understand how effective a drug might be and identify any potential side effects before moving on to testing in living organisms. Researchers look at several key factors to understand how a new drug works and how safe it is. They check how strongly the drug attaches to its target, how effective it is at doing its job, and how well it targets the right cells or molecules without affecting others. They also examine how the drug moves through the body, how long it stays active, and how it is broken down. Finally, they study whether the drug might cause any harmful side effects.
Promising candidates from in vitro studies then progress to in vivo testing. In vivo testing refers to experiments conducted in living organisms. "In vivo" is Latin for "within the living" and it involves administering the compound to animal models to evaluate its efficacy and safety in a living organism. This stage provides crucial data on the drug’s therapeutic potential, side effects, and appropriate dosages. Successful compounds show a good balance between working well and being safe. They help treat the disease effectively in tested objects without causing serious harm to the body.
Assessment of the efficacy of compounds in vivo has routinely involved the use of a variety of vertebrate species such as mice, rats, guinea pigs and birds. Although we can learn a lot from these species, there are ethical issues and costs involved resulting in the need for the development of alternative models. Due to the structural and functional similarities observed between the immune response of insects and mammals, insects are now being used to study the efficiency of novel anti-microbial and other drugs.
Insects have a fluid called haemolymph, similar to blood, which carries important molecules and helps defend against infections
Insects are a very common group of invertebrates. In addition, insects are a class of invertebrates consisting of over one million species that inhabit a wide range of ecological environments. This capacity to live in variable conditions and climates is suggestive of a highly effective immune response.
In contrast to vertebrates, who have evolved to develop a specific immune response, invertebrates maintained a robust natural defence system with many similarities to that of the insect. The insect's cuticle, like mammal skin, stops microbes from getting in. Insects also have a fluid called haemolymph, similar to blood, which carries important molecules and helps defend against infections.
Since the innate immune response of mammals is a vital component in their protection against infections, results obtained using insects show a strong correlation to those obtained using mice. From an ethical point of view, the use of insect screening models is a novel and efficient alternative that reduces both the number of animal models used and the amount of suffering imposed on animals, which studies have shown to have the mental capacity for consciousness.
Larvae of Galleria mellonella have been used to establish the toxicity profile for different compounds, including several anti-cancer drugs.
Given the similarities between mammalian and insect models with respect to susceptibility, subsequent disease pathologies and physiology, the use of insect screening can be used to investigate potential drug candidates. For example, a variety of different insect species have been employed to study microbe-host interactions: fruit fly Drosophila melanogaster, wax moth Galleria mellonella, the silkworm Bombyx mori and tobacco hornworm Manduca sexta. Furthermore, a wide range of microorganisms have been studied in insects including many disease-causing microorganisms.
Many insect models are currently available, but the use of larvae of the wax moth, Galleria mellonella, has been found to be most advantageous. They are inexpensive to purchase, results can be obtained within a couple of days and a large number of insects can be injected with specific amounts of drug or pathogen in a short period of time. As a result of these benefits, larvae of Galleria mellonella have been used to establish the toxicity profile for different compounds, including several anti-cancer drugs.
Once a compound demonstrates a favourable toxicity profile and efficacy in preclinical studies, including both in vitro and in vivo models such as Galleria mellonella, it progresses to the next stage, which is clinical trials. These human trials are conducted in phases to further assess safety, effectiveness and best dose in a bigger and more varied group of people. The entire drug development process, from initial idea to clinical trials, can span over a decade and involves rigorous regulatory scrutiny to ensure the safety and efficacy of the new drug before it can be approved for public use.
Follow RTÉ Brainstorm on WhatsApp and Instagram for more stories and updates
The views expressed here are those of the author and do not represent or reflect the views of RTÉ